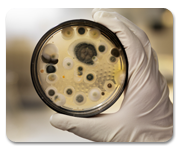

Microhealth Solutions is one of the world’s foremost providers of safe and long-lasting antimicrobial products that are easily applied to any surface or fabric. Our water based, non-toxic antimicrobial treatments are used to effectively minimize the presence of harmful microbial contaminants in a variety of industries, including but not limited to: health care, sports, fitness, hospitality, education, military, and at home.
Health Care

Preventing the spread of bacteria and infectious microbes is top priority in keeping a health care facility clean. Microhealth Solutions can help reduce hospital acquired infections by keeping touch points free of the germs and bacteria that can accumulate there. Keeping patients healthy and happy is your goal, and our products can help.
Sports and Fitness

Professional and recreational athletes alike are susceptible to bacteria and infectious germs in locker rooms and fitness centers around the world. Microhealth’s products are guaranteed to provide a long term solution for bacteria on surfaces and clothing, reducing the risk of common problems for athletes, such as MRSA infections.
Education

Schools and Universities are places feared for their dreaded “super bugs” that spread among students in classrooms everywhere. Microhealth’s revolutionary products, like BioShield 75, protect students from threats that accumulate on common touch points, in a safe, non-toxic way. Solutions that physically kill the dreaded “super bugs”, preventing microbial adaptation and lasting up to 90 days per application.
Military

Microhealth Solutions is proud to help the military prevent infections and disease anywhere soldiers are stationed. Being proactive in the prevention of these possible infections for our soldiers and their families is a responsibility that is taken very seriously, with no room for error.
Entertainment

Keeping a guest’s experience clean and sanitary is the first step taken for most entertainment venues. You can’t necessarily see BioShield 75 proactively and continually working to stop the growth of bacteria, but we guarantee a long lasting microbial protection as a direct result of its usage.
At Home

Our products make it simple and safe to fight the growth of harmful bacteria, mold, and fungi 24/7 on the surfaces and fabrics in your home. Our non-toxic solutions have been used to create antimicrobial barriers everywhere from hospital surgery rooms to the napping mats at hundreds of pre-schools across the country. Call or e-mail us today and find out how easily you can do the same in your home.
Janitorial Sanitation

Add value to your janitorial sanitation services by offering Microhealth Solutions’ innovative antimicrobial products and services. Your customers will appreciate the proactive and long lasting prevention of odorous bacteria that only our unique antimicrobial products can provide. Even more importantly is that they will WANT a comprehensive solution to illness-causing bacteria and mold that can thrive on surfaces and fabrics throughout a facility, and we can help you deliver it.
Mold Remediation
Microhealth Solutions’ revolutionary approach to microbial prevention makes it an ideal solution for the mold remediation process common after a flood or natural disaster. Effective against a broad spectrum of mold, bacteria and algae, BioShield 75 is the perfect defense against the growth of mold on surfaces. No matter the scale of the mold remediation project, Microhealth Solutions can meet your needs. Contact us today to start using BioShield 75 antimicrobial technology to enhance the effectiveness of your mold remediation process.
Transportation

Whether it’s minimizing the presence of bacteria on high-volume touch points in a mass transit vehicle or proactively preventing the smell of mildew that can permeate the cabin of a boat, the antimicrobial barrier created by Microhealth Solutions’ products can be easily incorporated into any car, bus, boat, train, or airplane to protect passengers from harmful microbes.
